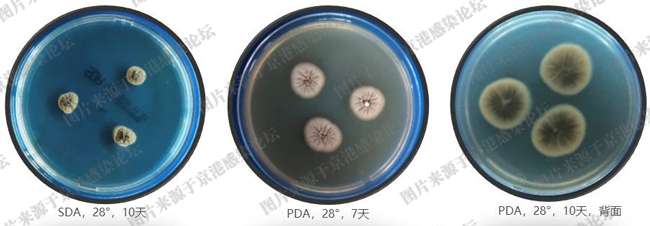
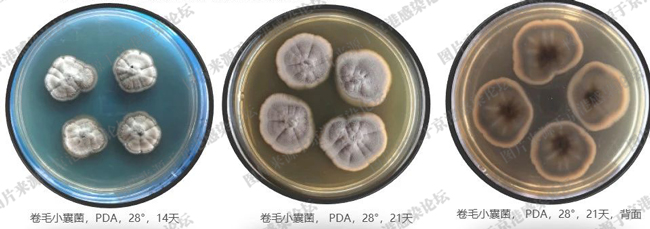
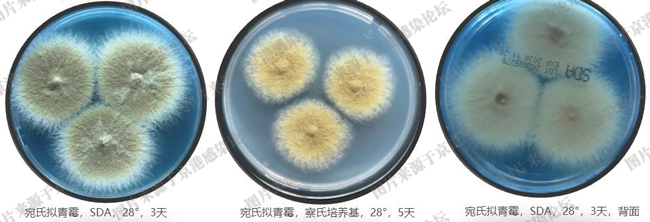
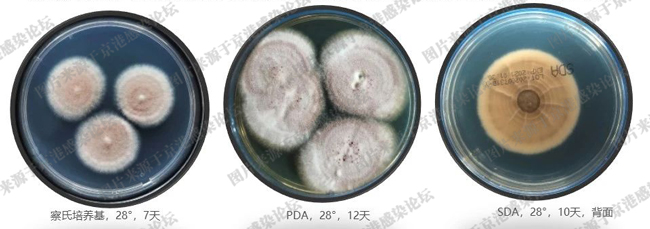
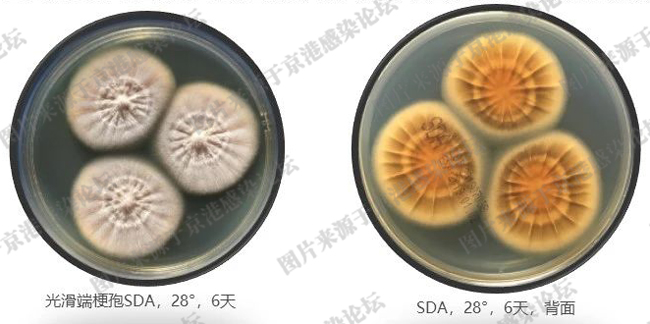
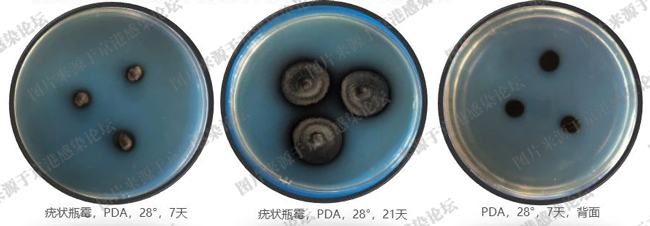
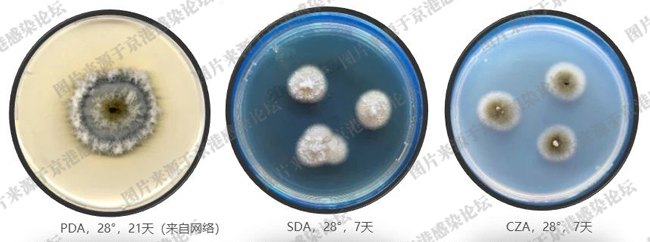
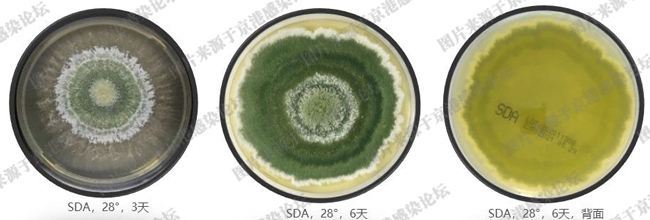
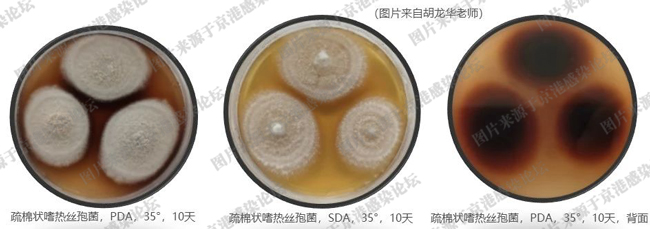
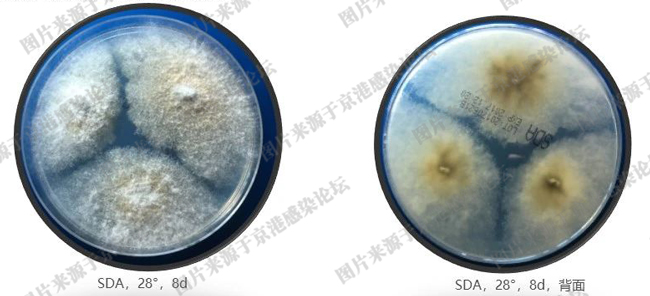

海博微信公众号
海博微信公众号
 海博天猫旗舰店
海博天猫旗舰店


 海博微信公众号
海博微信公众号
 海博天猫旗舰店
海博天猫旗舰店




1.多育节荚孢霉
原名多育赛多孢,土壤、污水、空气中均有发现,为条件致病菌。体外药敏显示,该菌对目前市面获批的抗真菌药物均显示耐药,有限临床治疗经验显示伏立康唑联合特比萘芬可能有一定的效果。
生长速度中等至快速,菌落平坦,开始为白色绒毛状,后变为棕色、橄榄绿色,背面为橄榄绿色。5天成熟,45℃可生长。

分生孢子梗基部膨大呈烧瓶状,环痕产孢。分生孢子单个或成束排列,与分生孢子梗连接的基部渐窄。
2.白僵菌属
通常为污染菌,偶可引起角膜炎、过敏性疾病、白血病患者全身播散性感染等,也是昆虫的病原菌。对两性霉素B中度敏感,对伊曲康唑、伏立康唑、泊沙康唑的MIC值较低。

菌落生长速度中等,多为白色,开始为棉絮状,延长培养变粉末状,背面白色。

分生孢子梗基部膨大呈瓶形,未端尖细成“之”字形弯曲小枝。于顶端小齿状结构产单细胞、卵圆形分生孢子,合轴产孢。陈旧培养时,产孢细胞聚集成簇。
3.小囊菌属
小囊菌可引起皮肤损害和甲真菌病,或引起着色芽生菌病或暗色丝孢霉病,亦可导致实验室内感染。对现有抗真菌药物存在高度耐药性。
菌落生长速度缓慢,多为棕色至橄榄色,延长培养背面呈棕色。

产孢细胞基部膨大,分生孢子淡褐色、链状排列、基部截平、向基性生长。子囊果球形或壶形,深棕色,内含子囊,子囊内含8个子囊孢子。
4.拟青霉属
代表菌种为宛氏拟青霉,耐高温,机会致病。对伏立康唑敏感度低,治疗上推荐泊沙康唑或两性霉素B。
菌落生长快速,粉状,沙黄色或黄棕色,反面淡黄色。

瓶梗单生或似帚状枝,基部膨大,顶部渐尖(管状体),分生孢子梭形、光滑、链状排列。可见厚壁孢子。
5.紫孢霉属
原来的淡紫拟青霉划入该属,改名为淡紫紫孢霉。条件致病,常见的感染是角膜炎。对两性霉素B和氟胞嘧啶天然耐药,特比萘芬联合伏立康唑的体外活性最好。淡紫紫孢霉可作为生态杀虫剂在农业中大量使用。
菌落生长中速,羊毛状,初期白色,逐渐变为淡紫色,反面淡黄色。

瓶梗单生或似帚状枝,基部膨大,顶部渐尖(管状体),分生孢子梭形、光滑或稍粗糙、链状排列。厚壁孢子常缺如。
6.端梗孢属
端梗孢具有嗜热性,40-50℃可生长。梭孢端梗孢和光滑端梗孢被报道是感染人类的致病菌,也是潜在嗜神经组织菌。对伏立康唑、泊沙康唑、伊曲康唑和特比萘芬敏感度较高。
菌落生长快速,开始白色,后中央逐渐变灰褐色至黑色,背面逐渐变黑.

分生孢子梗单生,较直立。瓶梗底部膨大,尖端逐渐变细,呈瓶型。分生孢子单细胞、柠檬形、链状排列,表面有螺旋带(光滑端梗泡除外)。
7.瓶霉属
疣状瓶霉为模式菌,条件致病,可导致着色芽生菌病、暗色丝孢霉病、真菌性足菌肿、角膜炎和心内膜炎等。伊曲康唑和卡泊芬净对瓶霉体外协同效果最好。
菌落生长速度慢,表面气生菌丝短而密,褐榄灰色至黑色,部分菌种可有放射沟纹或皱褶,背面黑色。

菌丝棕色至黑色。分生孢子梗呈瓶形,领口明显。分生孢子单细胞,基部常有瘢痕,在瓶口聚集成团呈花朵样。
8.单孢瓶霉属
单孢瓶霉从皮下组织中分离,可导致皮下组织真菌病。还有导致骨质溶解性暗色丝孢霉病、烧伤患者系统感染、新生儿心内膜炎、肾移植患者的腹膜炎等。本菌对棘白菌素类、泊沙康唑、特比萘芬、伏立康唑的MIC值较低,对两性霉素B的MIC值不定,5-氟胞嘧啶和氟康唑的MIC值≥32ug/ml。
菌落生长速度中等,湿润,平坦,无气生菌丝,白色或灰棕色、橄榄色。背面黑色。

产孢瓶梗生于菌丝中间,单生或丛生,棕色、厚壁,有一侧向的突起,在透明的顶端细胞侧面轮生瓶梗;囊领不明显,分生孢子单细胞,壁光滑,透明,聚集在粘液状假头处。陈旧培养偶尔可见厚壁孢子。
9.木霉属
为嗜热真菌,最高生长温度达48℃。通常作为污染菌出现,但也可导致人类感染。
菌落生长速度非常快,爆破式生长。开始为白色,很快菌落中央产绿色孢子,菌落周围有白色菌丝生长带,最后整个菌落变绿色,反面无色至黄色。

分生孢子梗对生、轮生或交错分枝,分枝几近直角。瓶梗瓶状,顶端渐尖,其上产生的分生孢子单细胞、椭圆形,聚集成团。
10.嗜热丝孢菌属
可在60℃生长,该菌广泛应用于发酵、酿造、医药生产和废物处理等领域。罕见致病,可导致人工瓣膜置换后心内膜炎、感染性心内膜炎。伊曲康唑、伏立康唑体外抗菌活性良好,两性霉素B体外抗菌活性差。
50-55℃培养,菌落生长快速。开始为白色,后转为灰绿色至黑色,可产生粉色至葡萄酒色色素。

分生孢子梗短,直立,中间膨大,不分枝或不规则分枝。分生孢子单生、球形、壁厚。
11.节菱孢属
为常见的腐生菌,常分离自皮肤标本,多数情况下为污染菌,偶尔可引起皮肤感染和甲癣。节茭孢可引起农作物感染,并可产生剧毒物质。
菌落生长快速,棉絮状。开始为白色,后变成淡黄色,背面淡黄色。随着培养时间延长,可变成暗色。

分生孢子梗直立(或略弯曲)于烧瓶状的母细胞上。分生孢子橄榄球状,棕黑色,有赤道样环绕一周的芽缝。
12.其他

双相真菌中的皮炎芽生菌、伊蒙菌和新伊蒙菌,24℃培养(霉菌相),镜下可见部分产孢细胞膨大。
“大腹便便”真菌形态学总结


来源:京港感染论坛 广西壮族自治区妇幼保健院检验科 刘敏雪
提醒:本文章所有内容均来源网络,仅用于学习交流,若有侵权内容,请及时联系删除或修改,特此声明!
上一篇:麸皮硫酸铵桔皮粉培养基
下一篇:噬菌体载体
| 相关文章: |



